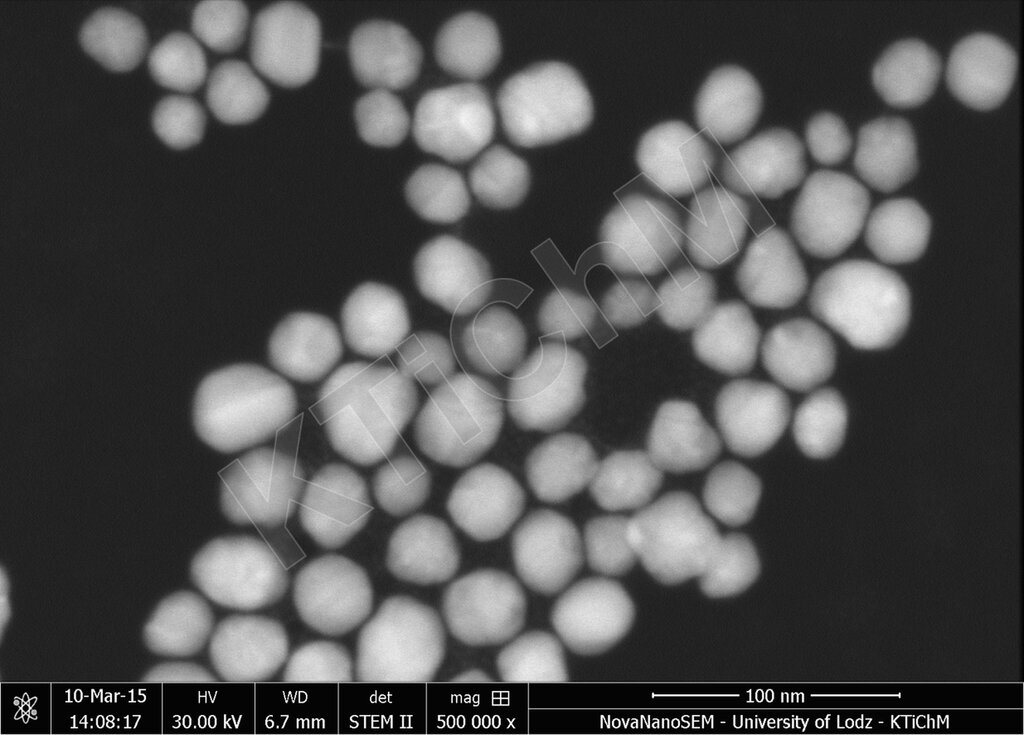
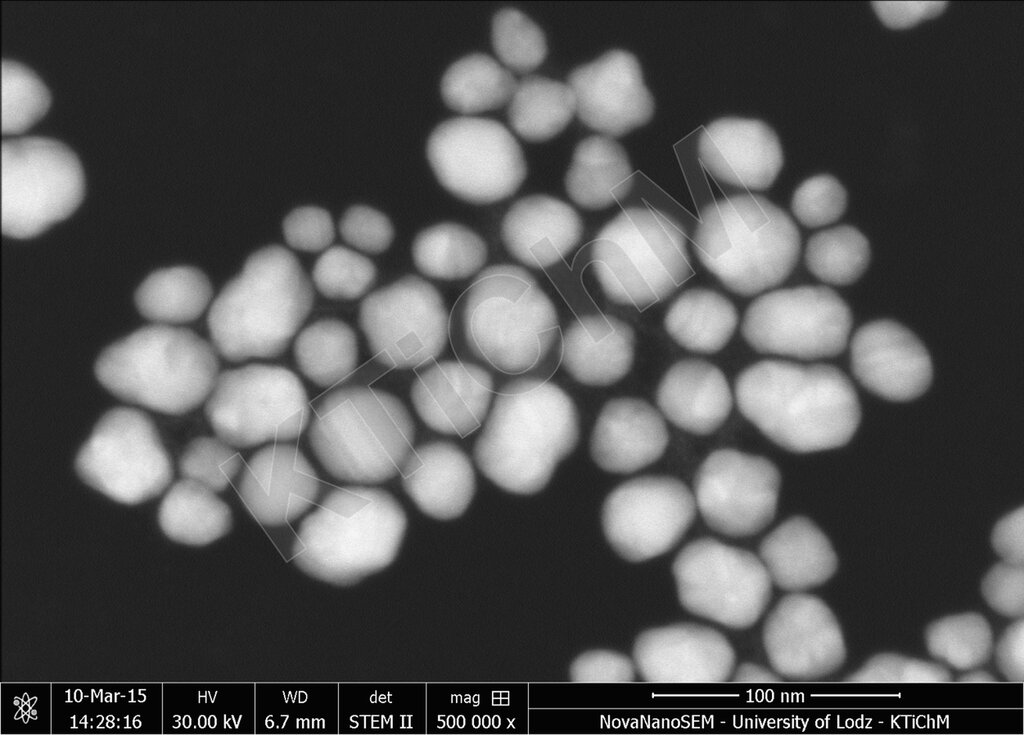

- Uniwersytet Łódzki
- Wydział Chemii Uniwersytetu Łódzkiego
- Katedra Technologii i Chemii Materiałów
- Nanocząstki srebra
Wydział
Nauka i badania
- Profil naukowy
- Komisja Uniwersytetu Łódzkiego do spraw stopni naukowych w dyscyplinie nauki chemiczne
- Publikacje
- Doktoraty
- Habilitacje
- Profesury
- Scienceon
- Centra Naukowe
- Nagrody Rektora
- Naukowa Nagroda Dziekana
- Nagroda im. Profesora Romualda Skowrońskiego
- Popularyzacja Nauki
- Wsparcie w nauce i badaniach
-
Wydział
-
-
-
-
-
Brak elementów do wyświetlenia
Katedra Technologii i Chemii Materiałów
Nasza strona internetowa używa plików cookies (tzw. ciasteczka) w celach statystycznych, reklamowych oraz funkcjonalnych. Dzięki nim możemy indywidualnie dostosować stronę do Twoich potrzeb. Każdy może zaakceptować pliki cookies albo ma możliwość wyłączenia ich w przeglądarce, dzięki czemu nie będą zbierane żadne informacje
Przejdź do strony
polityka prywatności